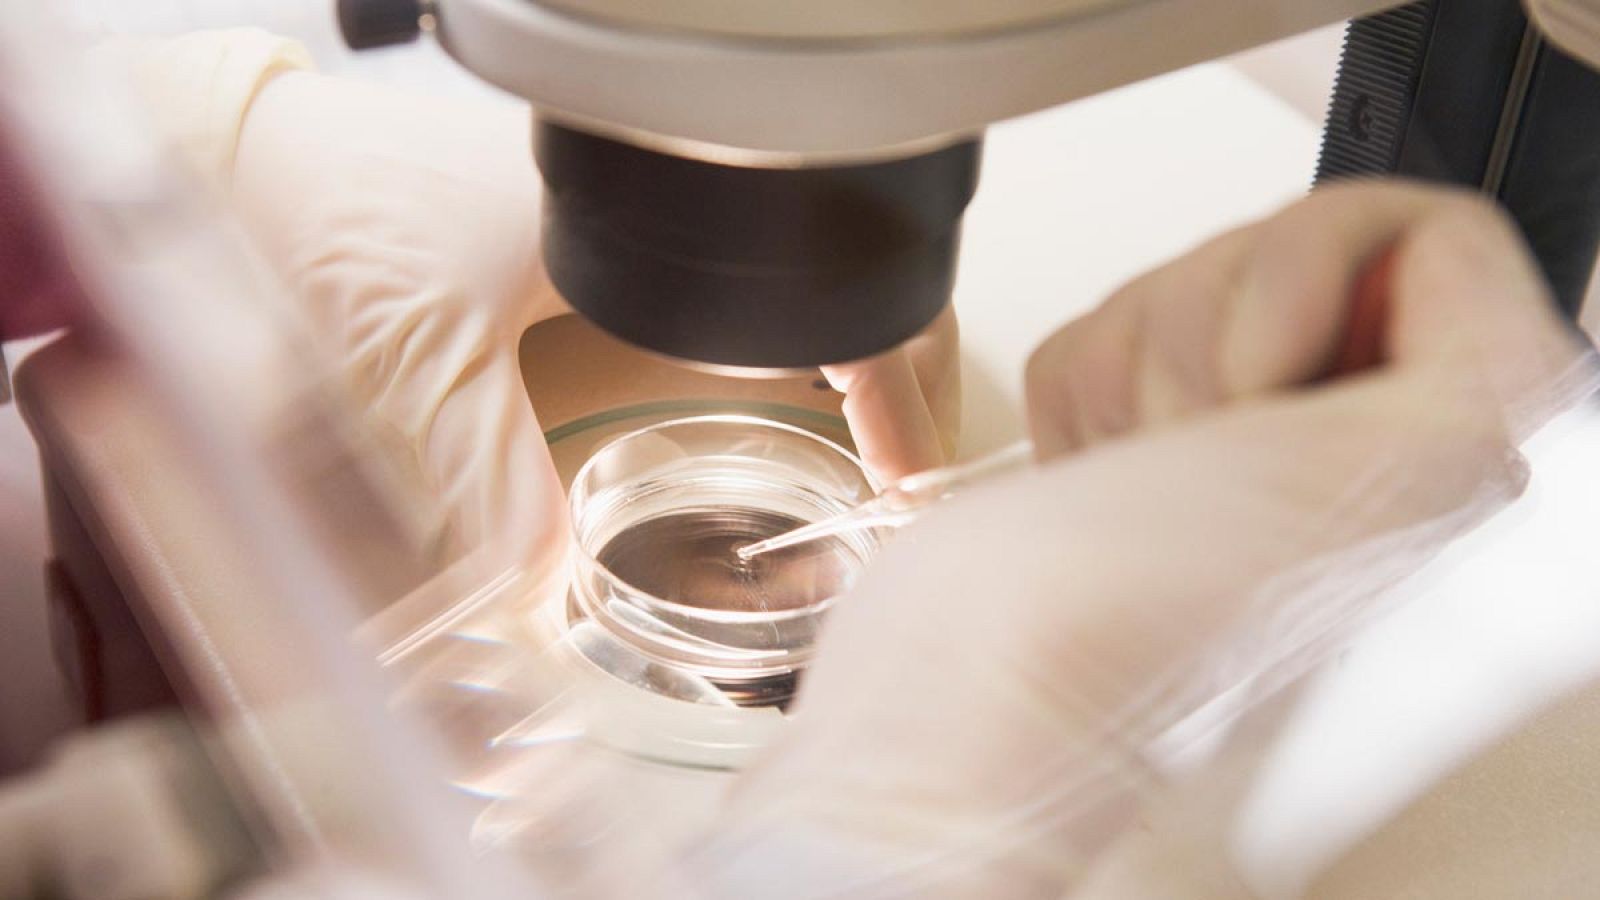
El estudio proporcionaría información avanzada acerca del estado del embrión.

Desarrollan una técnica que permite conocer el estado de salud de los embriones
- Ha sido capaz de producir imágenes de embriones vivos de ganado
- Ayudaría a seleccionar aquellos que se encuentran en mejores condiciones
- Podría ayudar al desarrollo de la fecundación in vitro en humanos

Un grupo de investigadores de la Universidad de Illinois (Estados Unidos) ha creado una nueva técnica para producir imágenes de embriones vivos de ganado que pueden ayudar al desarrollo de la fecundación in vitro en humanos.
El estudio, publicado en la revista Nature Communications, proporcionaría información avanzada acerca del estado del embrión y ayudaría a los médicos a seleccionar aquellos que tienen más probabilidades de llevar a embarazos exitosos.
Esta información podría ser útil para las parejas que tienen problemas de fertilidad, teniendo en cuenta que un tratamiento de fecundación puede costar alrededor de 20.000 dólares (casi 17.000 euros), lo que aumenta el deseo de acertar en el primer intento.
El nuevo método, que se ha probado en una vaca, consiste en filtrar luz a través de los tejidos con el objetivo de crear una imagen del embrión. Esta técnica también resuelve los problemas que ocasionaban otros métodos químicos o físicos y suponían un riesgo tóxico para el tejido vivo.
"Uno de los santos griales de la embriología es encontrar una manera de determinar de una manera no invasiva qué embriones son más viables", señala uno de los autores de la investigación, Matthew Wheeler.
Aún no hay un marcador universal
Los análisis del embrión para poder determinar su desarrollo se realizan a través de la observación de los fluidos de células, aunque, según Wheeler, "todavía no hay un marcador universal para diagnosticar con exactitud el estado de salud del embrión". Otro de los científicos, Marcello Rubessa, apunta que la prueba definitiva de la utilidad de este hallazgo será "escoger el embrión sano" y desarrollar con él "un ternero vivo".
El equipo de investigadores espera que esta técnica pueda aplicarse a los tratamientos de fertilidad humana, así como a diferentes estudios de tejidos animales que sirvan para el desarrollo científico en la materia.



